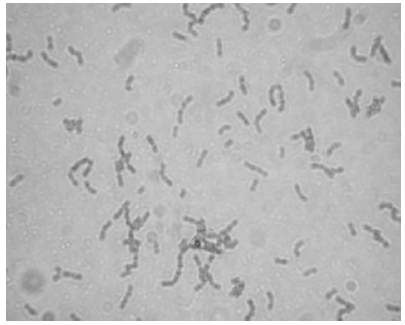
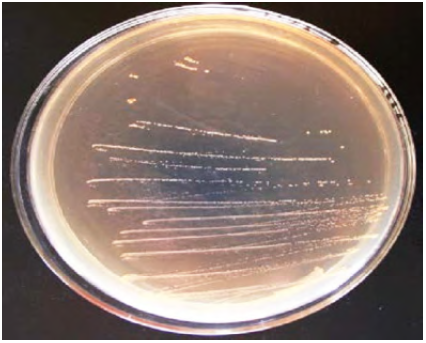

复合诱变选育新型高产细菌素植物乳杆菌
来源: 作者: 发布时间:2019-09-12 17:09 浏览量:156
本期为您推荐黑龙江八一农垦大学,黑龙江省农产品加工与质量安全重点实验室,国家杂粮工程技术研究中心,中国海洋大学食品科学与工程学院王颖,张东杰研究团队发表在《中国生物制品学杂志》上的一篇文章:复合诱变选育新型高产细菌素植物乳杆菌。
文章摘要内容如下:
目前,抗生素滥用导致的病原体耐药性及食品中防腐剂对机体的毒副作用等问题与日俱增。因此,开发新型无毒的生物防腐剂不仅为食品工业的重要发展方向,更是食品质量及安全的研发攻关热点。乳酸菌分泌的细菌素具有天然无毒和无残留等优势,因其绿色安全的抑菌效果而在食物保藏领域中脱颖而出。传统细菌素主要抑制革兰染色阳性菌,而低温腐败菌却多为革兰染色阴性菌。
本研究从东北传统发酵肉制品中分离和再诱变选育广谱高产细菌素的植物乳酸菌,并对其进行鉴定。经过四轮复合诱变[微波诱变、亚硝基胍(nitroso-guanidin,NTG)诱变、常压室温等离子体(atmospheric room temperature plasma,ARTP)诱变、紫外诱变]具有降胆固醇能力的植物乳杆菌M1株,获得还可产生广谱细菌素的植物乳杆菌。对其进行稳定性、微生物形态特征、生理生化特征及PCR鉴定。结果表明,原始菌株经四轮复合诱变后获得1株高产细菌素菌株,该菌株兼具遗传稳定性、优良发酵特性和抑菌功效,且抑菌谱较宽,兼具降胆固醇和防腐的优良加工特性,工业化推广前景广泛。鉴定该菌株为植物乳杆菌,命名为M1-UVs300,其分泌的细菌素命名为M1-UVs301;菌株保藏号为CGMCC NO.7972。
文章精彩内容如下:

图3 ARTP诱变致死率及正突变率曲线
图5 植物乳杆菌M1-UVs300菌株的显微照片(10×100)
图6 植物乳杆菌M1-UVs300菌株菌落形态

图7 植物乳杆菌M1-UVs300 PCR产物电泳图(M:DNA marker DL2000;1:菌株PCR产物;2:空白对照)
